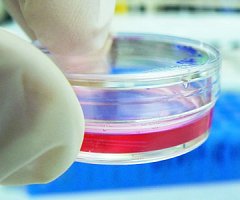
Consiguen regenerar por completo la piel de ratones mediante células madre

2014
-
-
The Enrichment Record: Volúmen 18 (PDF)
16 February 2014 -
Humedad elevada en sala de animales: ¿Qué hago?
15 February 2014 -
-
-
Avance argentino en la lucha contra el cáncer
15 February 2014 -
Nuevo avance argentino en la lucha contra el cáncer
14 February 2014 -
-
-
Avances en la evaluación de la seguridad sin animales: EURL CEVMA
09 February 2014